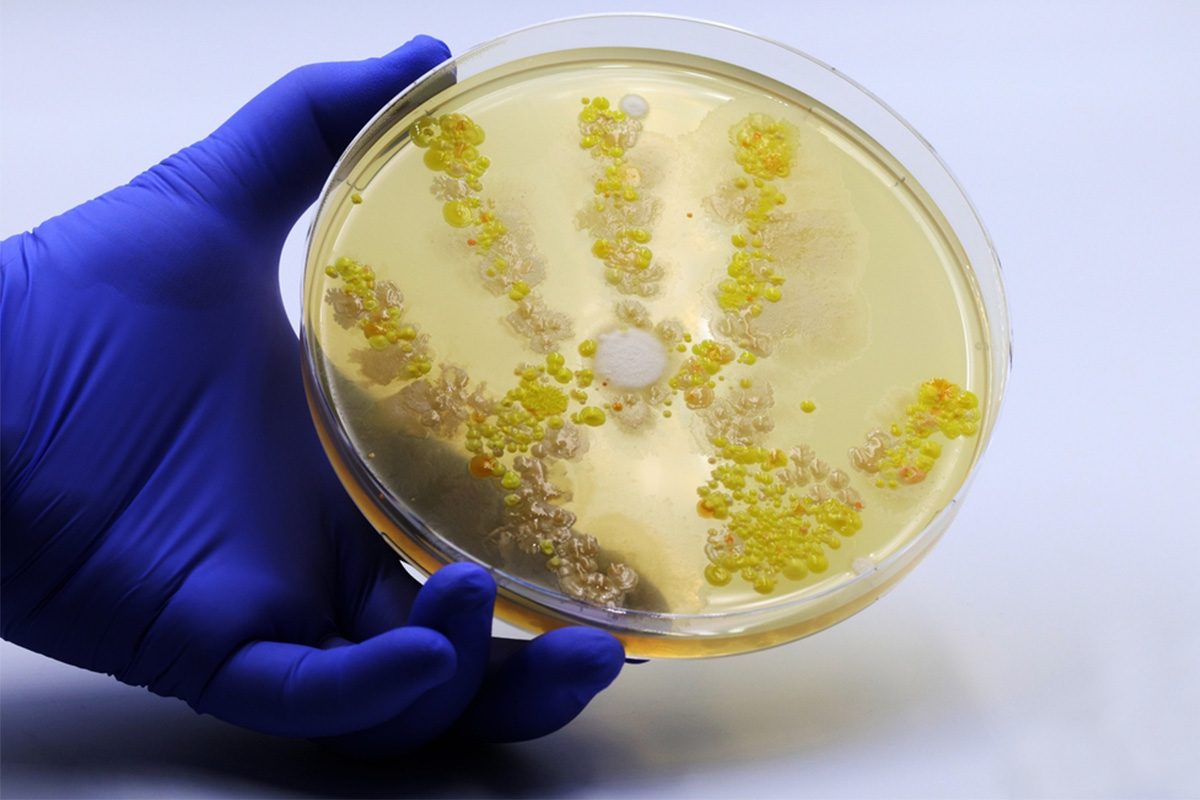

أدوات داخل منزلك قد تحتوي على سموم وآثار صحية تنعكس عليك انتبهي منها وسنطلعك عليها في هذا المقال بعدما تطرقنا سابقاً إلى تأثيرات غير متوقعة للبيت النظيف على صحة عائلتك.
حذر تقرير لشبكة “سي أن أن” الأميركية من مادة كيميائية ارتبطت ببعض أنواع السرطان والاضطرابات الايضية، وسنطلعك هنا على بعض التفاصيل حولها.
مادة كيميائية موجودة في نحو 45% من عينات المياه
تقول شبكة “سي أن أن” في تقرير إخباري لها إن المواد الكيميائية الأبدية، مثل مادة “PFAS” الكيميائية أو مواد “Polyfluoroalkyl”، أو “perfluoroalkyl”، (مواد ألكيل مشبعة بالفلور ومتعددة الفلور)، ويطلق عليها اسم المواد الكيميائية الأبدية لأنها تتحلل ببطء شديد، وتستخدم هذه المواد الكيميائية بشكل شائع في المنتجات المستخدمة يومياً مثل أدوات القلي غير اللاصقة أو بعض عبوات الطعام.
واختبر باحثون في دراسة جديدة عينات من مياه الصنوبر بحثاً عن مادة “PFAS”، وأخذت هذه العينات من أكثر من 700 موقع في أنحاء الولايات المتحدة الأميركية ضمناً الآبار الخاصة والمصادر العامة، ووجد الباحثون أن هذه المادة موجودة في حوالي 45% من عينات مياه الشرب وكانت أكثر موجودة في المناطق الحضرية مقارنة مع المناطق الريفية.
وتلفت الشبكة إلى أن هذه النتائج لا تهدف إلى إخافة الناس، لكنها سبب إضافي لاستخدام فلاتر الكربون المنشط في مياه الصنوبر بالمنزل، فقط تذكروا تغييرها بانتظام.
وارتبطت هذه المادة ببعض أنواع السرطان والاضطرابات الأيضية، ولا يزال هناك بحث جار حول المزيد من الآثار الصحية العامة لاتي قد تتسبّب بها هذه المواد الكيميائية.
لذلك، فإنه من المهم أن تحافظي على منزلك نظيفاً ومرتباً طوال الوقت وأن تحارب التلوث والسموم في البيت خصوصاً إذا كان لديك أولاد.
ما هي PFAS؟
تعتبر PFAS عائلة من المواد الكيميائية الاصطناعية التي تبقى في البيئة وجسم الانسان، وأفادت وكالة حماية البيئة الأميركية، أن التعرّض لمواد PFAS يرتبط بأمراض السرطان، والسمنة، وأمراض الغدة الدرقية، وارتفاع الكوليسترول، وتدني الخصوبة، وتلف الكبد، وقمع الهرمونات.
وأفادت دراسة صادرة عن هيئة المسح الجيولوجي الأميركية، أن قرابة نصف مياه الصنوبر في الولايات المتحدة ملوثة بمواد كيميائية تعرف باسم “المواد الكيميائية الأبدية”.
في السياق، اليك نصائح لادخال الطاقه الايجابيه في المنزل! يمكنك الاستفادة منها.
